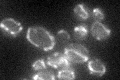

View description
Mitochondrial protein involved in protein import into the mitochondrial matrix; maintains the functional integrity of the TIM23 protein translocator complex; viability of null mutant is strain-dependent; mRNA is targeted to the bud
Localization:
Intensity:
Fold change:
Significance:
-
C’ GFP library in SD
mitochondria28.68 -
N' NOP1pr-GFP in SD

mitochondria71.4302 -
N' TEF2pr-mCherry in SD

missing0 -
N' NATIVEpr-GFP in SD

mitochondria25.5761 -
N' TEF2pr-VC and Cyto-VN in SD

#N/A0 -
C’ GFP library in SD+DTT

mitochondria29.871.04No -
C’ GFP library in SD+H2O2

mitochondria30.371.05No -
C’ GFP library in Starvation Media

mitochondria55.761.94Yes -
C’ GFP library on the background of Pup2-DaMP

mitochondria -
C’ GFP library on the background of CCT mutant

mitochondria31.64081.10301No
